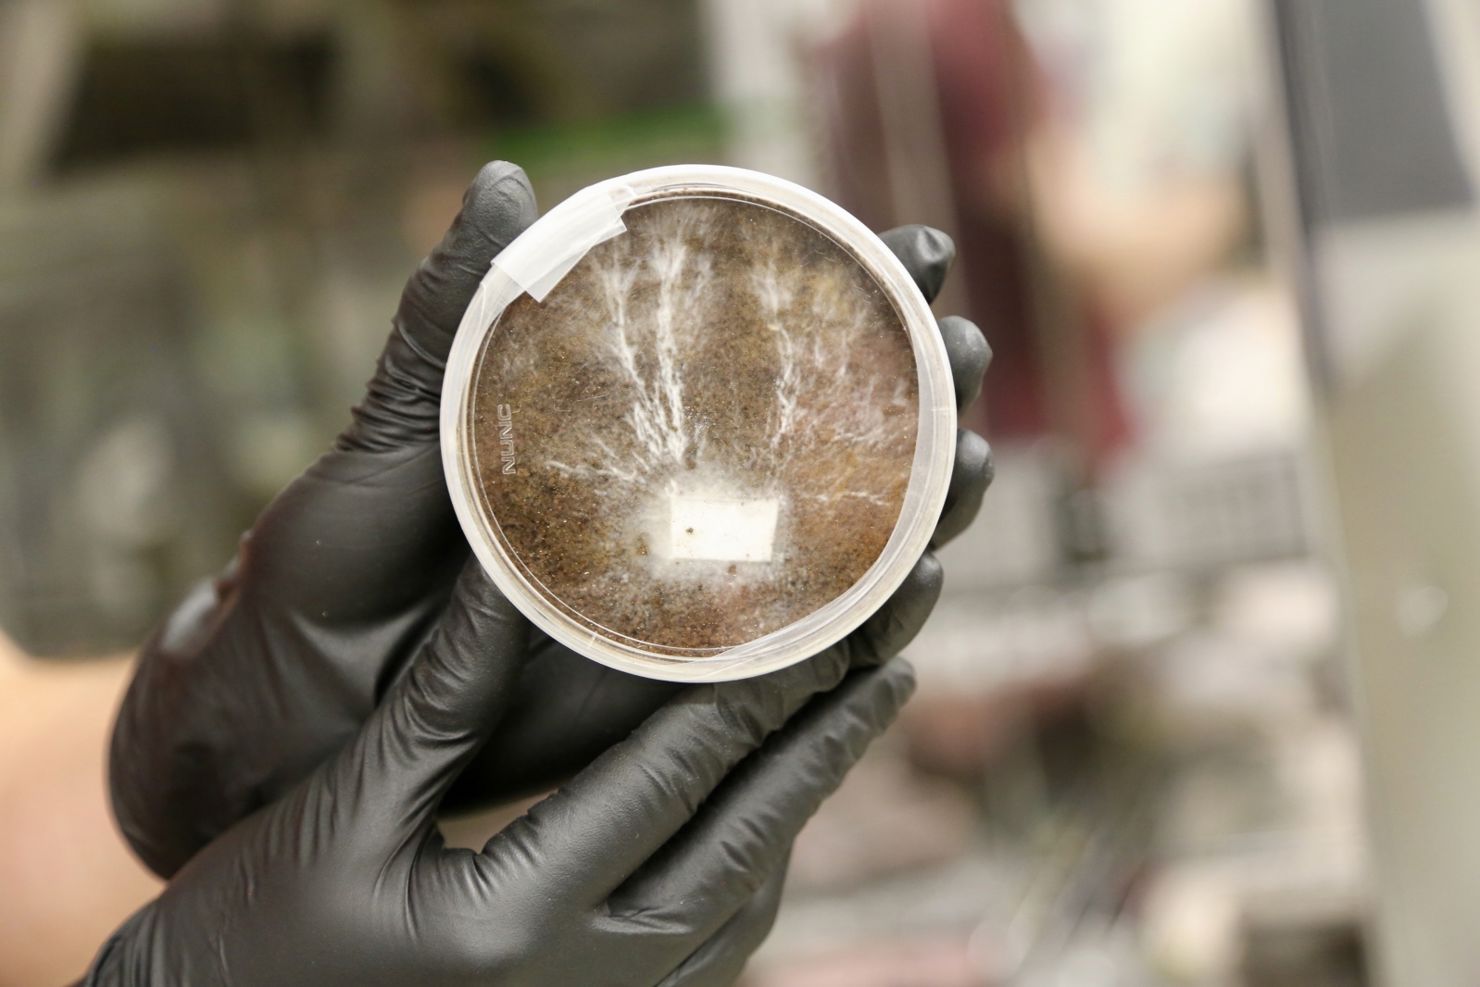
Är framtida hus på månen och Mars gjorda av svamp?

Det hårda klimatet på månen och Mars kommer kräva nya sätt att bo och en del av det kanske är att odla sina hem istället för att bygga dem. Där kan svampen mycelia vara ett sätt att designa hållbara och miljövänliga boendelösningar.
Vid Nasas Ames Research Center i Silicon Valley, Kalifornien, pågår just nu ett projekt som kallas myco-architecture project. I projektet tar man fram prototyper på teknologier som kan odla hem utav svampsorten. Visionen är att framtida rymdfarare ska kunna ta med sig lätta, kompakta hem, men som kommer hålla under en längre tid, som vid resor till Mars exempelvis. Vid ankomst tar man då fram en lätt stomme, adderar vatten till svampen som sedan växer runt stommen till ett fullt fungerande hem. Dessutom utan att förorena Mars miljö med onaturliga material.